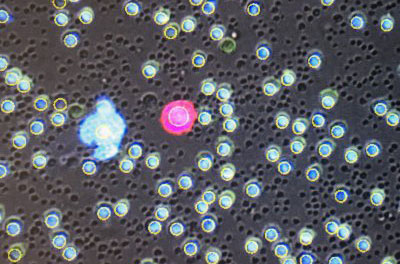

通过分析血液中循环肿瘤细胞(CTC)的数量,可以控制癌症治疗的成功。这些ctc的存在反映了肿瘤生长的迹象,并使一种监测它的方法成为可能。不幸的是,血液中ctc的浓度很低,很难捕捉到它们。
SYNENTEC成像平台(CELLAVISTA®和NYONE®)打开了一种方法,以快速和可靠的方式检测这些罕见事件。YT-Software®软件包使用嵌入式处理工具从数千个血细胞中提取ctc进行量化。
通过分析血液中循环肿瘤细胞(CTC)的数量,可以控制癌症治疗的成功。这些ctc的存在反映了肿瘤生长的迹象,并使一种监测它的方法成为可能。不幸的是,血液中ctc的浓度很低,很难捕捉到它们。
SYNENTEC成像平台(CELLAVISTA®和NYONE®)打开了一种方法,以快速和可靠的方式检测这些罕见事件。YT-Software®软件包使用嵌入式处理工具从数千个血细胞中提取ctc进行量化。